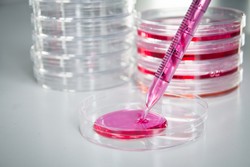

Un nuovo approccio alla separazione delle cellule staminali
La caratterizzazione e la separazione delle popolazioni di cellule staminali è normalmente eseguita tramite citometria a flusso. Diversi fattori limitano le attuali tecnologie di separazione, come la mancanza di anticorpi specifici, la bassa concentrazione di cellule staminali e la necessità di marcatori a fluorescenza. Il progetto SAVVY(si apre in una nuova finestra) (Self-assembled virus-like vectors for stem cell phenotyping) si proponeva di sviluppare un approccio differente alla separazione cellulare, basato su particelle. L’idea principale era di utilizzare le firme molecolari di popolazioni eterogenee di cellule staminali per permetterne l’efficace separazione. Il progetto ha utilizzato le differenze intrinseche nella composizione delle membrane cellulari per distinguere e poi separare le popolazioni di cellule staminali. L’approccio di SAVVY non ha bisogno di anticorpi, aptameri o altri biomarcatori, è label-free (non utilizza marcatori fluorescenti né coloranti) ed è riproducibile a prezzi accettabili. Questo approccio si basa sull’assemblaggio multiscala di nanoparticelle (NP) simili a virus intrinsicamente dissimili per sviluppare nuovi tipi di sonde multifunzionali per la spettroscopia Raman. Il sistema di separazione di cellule vive, una volta completato, deve incorporare amplificatori di segnali basati sulle NP e spettroscopia Raman in un separatore cellulare microfluidico integrato. I ricercatori sono riusciti a sviluppare progetti in cui le superfici interne degli emisferi dei vettori sono controllati e funzionalizzati in modo indipendente. Hanno prodotto culture di cellule staminali umane e protocolli di differenziazione specifici in formati che sono accessibili dalla spettroscopia Raman. Il consorzio SAVVY è riuscito a verificare tutte le fasi di processo del sistema basato sulla microfluidica, come la separazione delle particelle/cellule, l’isolamento di singole cellule, l’analisi Raman e la separazione cellulare. Ciascuno di questi moduli era caratterizzato e dopo l’ottimizzazione è stato selezionato un modulo per ogni fase funzionale Il progetto SAVVY ha fornito una prova di concetto affinché le popolazioni di cellule staminali siano identificate/analizzate e separate tramite spettroscopia Raman multifunzionale usando come sonde NP simili a virus dissimili. Le scoperte del progetto dovrebbero aiutare i ricercatori a superare difficoltà legate al limitato numero di anticorpi disponibili e di marcatori fluorescenti adatti per la ricerca sulle cellule staminali. L’approccio SAVVY alla fenotipizzazione e separazione è importante per le terapie a base di cellule staminali, la rigenerazione dei tessuti e nuove tecnologie mediche. Questa tecnologia potrebbe portare a nuovi strumenti diagnostici applicabili a diverse patologie.